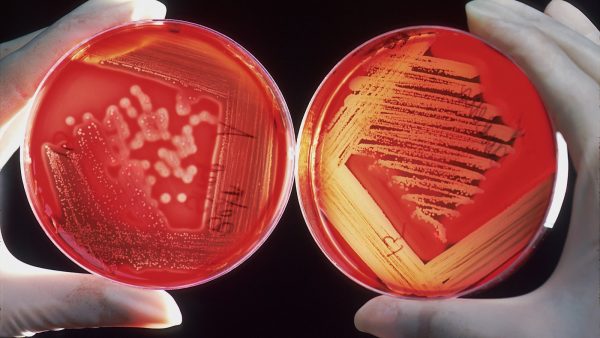
Usos del agar agar

Contenido
- 1. ¿Qué es el Agar Agar?
- 2. Propiedades del Agar Agar
- 3. Usos culinarios del Agar Agar
- 4. Aplicaciones del Agar Agar en la industria alimentaria
- 5. Usos del Agar Agar en productos farmacéuticos y de belleza
- 6. El Agar Agar como alternativa vegetal a la gelatina
- 7. Beneficios del uso del Agar Agar para la salud
- 8. Consejos para utilizar el Agar Agar en la cocina y la industria
- Aditivo alimentario natural - no altera el sabor de los alimentos
- Ideal para jaleas de frutas, mermeladas, budines, bávaros, helados y cocina molecular (ideal para la esferificación)
- Soluble en agua caliente a 80 ° C - reacciona en enfriamiento hacia 42-32 ° C - gelificante medio 600 +/- g / cm2
- Pureza 100% - no contiene gluten
- Excelente sustituto de gelatinas de origen animal
El agar agar es un polisacárido obtenido a partir de diversas algas rojas. En la cocina y la industria alimentaria, este ingrediente se ha convertido en un elemento cada vez más común debido a su capacidad para espesar y gelificar, siendo utilizado en una gran variedad de productos y platillos. A continuación, presentamos una guía sobre los diferentes usos del agar agar, desde sus aplicaciones culinarias hasta sus beneficios en la salud.
1. ¿Qué es el Agar Agar?
El Agar Agar es un aditivo alimentario natural que se utiliza en la preparación de postres, helados, mermeladas y otros productos alimenticios, para mejorar su textura. Este producto se extrae de algas marinas y es muy utilizado en la gastronomía vegetariana y vegana, ya que funciona como gelificante y espesante.
El Agar Agar es un producto ampliamente utilizado en la industria alimentaria, ya que no altera el sabor o el color de los alimentos. Además, cuenta con propiedades beneficiosas para la salud, como la regulación del tránsito intestinal y la prevención de enfermedades como la osteoporosis.
- El Agar Agar no contiene grasas ni calorías, por lo que es perfecto para quienes buscan cuidar su figura y alimentarse de manera saludable.
- Se utiliza en la elaboración de algunos productos farmacéuticos y cosméticos, gracias a sus propiedades hidratantes y antienvejecimiento.
2. Propiedades del Agar Agar
El agar agar es un producto natural que proviene de las algas marinas. Sus propiedades hacen de este un producto muy versátil en la cocina y en la industria alimentaria.
- Gelificante: El agar agar se utiliza para dar consistencia gelatinosa a diversos productos.
- Estabilizante: Gracias a su capacidad para retener agua, el agar agar es utilizado en la elaboración de helados, yogures y otros productos que necesitan mantener su estabilidad.
- Bajo en calorías: A diferencia de otros espesantes, el agar agar es bajo en calorías y no tiene sabor.
Otras propiedades incluyen su capacidad para producir espumas, emulsiones y estabilizar líquidos. Además, el agar agar se utiliza en la medicina alternativa como laxante y como agente reductor del colesterol.
3. Usos culinarios del Agar Agar
:
El Agar Agar es un ingrediente cada vez más popular en la cocina, especialmente en la comida vegana y vegetariana. Aquí tienes algunos de los usos culinarios más comunes del Agar Agar:
- Postres: el Agar Agar es ideal para hacer pudines, mermeladas, gelatinas y otros postres vegetales. Algunos de los beneficios de usar Agar Agar es que no tiene sabor, es fácil de usar y tiene una gran capacidad para cuajar.
- Sopas y caldos: el Agar Agar se utiliza a veces para espesar sopas y caldos.
- Bebidas: el Agar Agar puede ser utilizado como espesante en bebidas y batidos.
4. Aplicaciones del Agar Agar en la industria alimentaria
El Agar Agar es uno de los ingredientes más utilizados en la industria alimentaria debido a sus múltiples aplicaciones como espesante, gelificante y estabilizante. Algunas de las aplicaciones más comunes son:
- En la producción de helados para mejorar su textura y consistencia.
- En la elaboración de mermeladas y jaleas para lograr una consistencia firme y sin separación de líquidos.
- En la preparación de postres como flanes y natillas para evitar la separación de los líquidos y lograr una textura cremosa.
- En la producción de salsas y aderezos para darles una textura espesa y consistente.
Además de su uso en la industria alimentaria, el Agar Agar también es utilizado en otras áreas como la industria farmacéutica y cosmética debido a sus propiedades como agente espesante y gelificante.
5. Usos del Agar Agar en productos farmacéuticos y de belleza
El Agar Agar es un ingrediente muy versátil que se encuentra en diferentes productos farmacéuticos y de belleza. Aquí te presentamos algunos de los usos más comunes que tiene:
- Formulación de cápsulas y tabletas: El Agar Agar se utiliza como agente espesante y estabilizador en la elaboración de comprimidos y cápsulas, lo que permite que la medicación se desintegre en el intestino de manera gradual.
- Geles y cremas: Este ingrediente es muy utilizado en la elaboración de geles y cremas para la piel, ya que actúa como espesante y emulsionante, otorgando una textura suave y sedosa.
- Productos para el cuidado del cabello: El Agar Agar es utilizado en champús y acondicionadores como agente espesante y astringente, dejando el cabello más suave y manejable.
Además, el Agar Agar también es utilizado en la industria de cosméticos y como excipiente en la elaboración de algunos medicamentos. Su uso es seguro y no tiene efectos secundarios.
6. El Agar Agar como alternativa vegetal a la gelatina
El agar agar es una alternativa vegetal a la gelatina, ideal para vegetarianos y veganos. Aquí te explicamos todo lo que necesitas saber:
- Se obtiene de algas marinas y es rico en fibra y minerales.
- Se puede utilizar igual que la gelatina en postres y platos dulces y salados.
- No tiene sabor ni olor, por lo que no alterará el sabor de tus recetas.
- Es una opción más saludable, baja en calorías y sin colesterol.
Prueba esta alternativa para una opción más respetuosa con los animales y para cuidar tu salud.
7. Beneficios del uso del Agar Agar para la salud
- El agar agar controla los niveles de colesterol en sangre y previene enfermedades cardiovasculares.
- Regula el tránsito intestinal y previene el estreñimiento, actuando como un prebiótico natural.
- Es ideal para personas que tienen problemas de obesidad, ya que es bajo en calorías y ayuda a controlar el apetito.
- Contiene minerales como calcio, hierro y magnesio, beneficiosos para la salud ósea.
- Se utiliza en la medicina tradicional oriental para tratar problemas respiratorios y de piel.
8. Consejos para utilizar el Agar Agar en la cocina y la industria
- No sobrepasar la cantidad recomendada: si se añade demasiado Agar Agar podría volver la preparación muy densa y gomosa.
- Mezclar con cuidado: el Agar Agar en polvo debe ser agregado en pequeñas cantidades a la preparación y mezclado a fondo cada vez para evitar grumos.
- Tiempo de cocción: el Agar Agar necesita ser cocido a alta temperatura durante al menos 3-5 minutos para que se active su acción gelificante.
- Temperatura: el Agar Agar se solidifica a temperatura ambiente, pero puede perder su consistencia al ser sometido al calor. Es recomendable mantener la preparación en el refrigerador para mantener su textura.
En la industria, el Agar Agar es utilizado como espesante, estabilizante y agente gelificante en productos alimenticios. Para utilizar en la industria es importante seguir las instrucciones y cantidades recomendadas por el proveedor para evitar resultados negativos de textura o sabor.
El Agar Agar es una opción vegana y sin gluten para la cocina y la industria alimentaria. Al seguir estos consejos su uso será efectivo y permitirá lograr la textura y consistencia deseada en las preparaciones.
¡No esperes más! ¡La mejor manera de ahorrar en tus compras!
Los siguientes productos te podrían interesar:
- Aditivo alimentario natural - no altera el sabor de los alimentos
- Ideal para jaleas de frutas, mermeladas, budines, bávaros, helados y cocina molecular (ideal para la esferificación)
- Soluble en agua caliente a 80 ° C - reacciona en enfriamiento hacia 42-32 ° C - gelificante medio 600 +/- g / cm2
- Pureza 100% - no contiene gluten
- Excelente sustituto de gelatinas de origen animal
- Gelificante
- Ideal para elaborar espumas
- Ideal para platos fríos y calientes
- Producto envasado en instalaciones donde también se manipulan derivados de la leche, el huevo, soja y sulfitos.
- Por motivos de seguridad alimentaria, la normativa de la UE no permite la devolución de productos de alimentación.
- Aditivo alimentario natural - no altera el sabor de los alimentos
- Ideal para jaleas de frutas, mermeladas, budines, bávaros, helados y cocina molecular (ideal para la esferificación)
- Soluble en agua caliente a 80 ° C - reacciona en enfriamiento hacia 42-32 ° C - gelificante medio 600 +/- g / cm2
- Pureza 100% - no contiene gluten
- Excelente sustituto de gelatinas de origen animal
Última actualización el 2026-03-01 / Enlaces de afiliados / Imágenes de la API para Afiliados

















